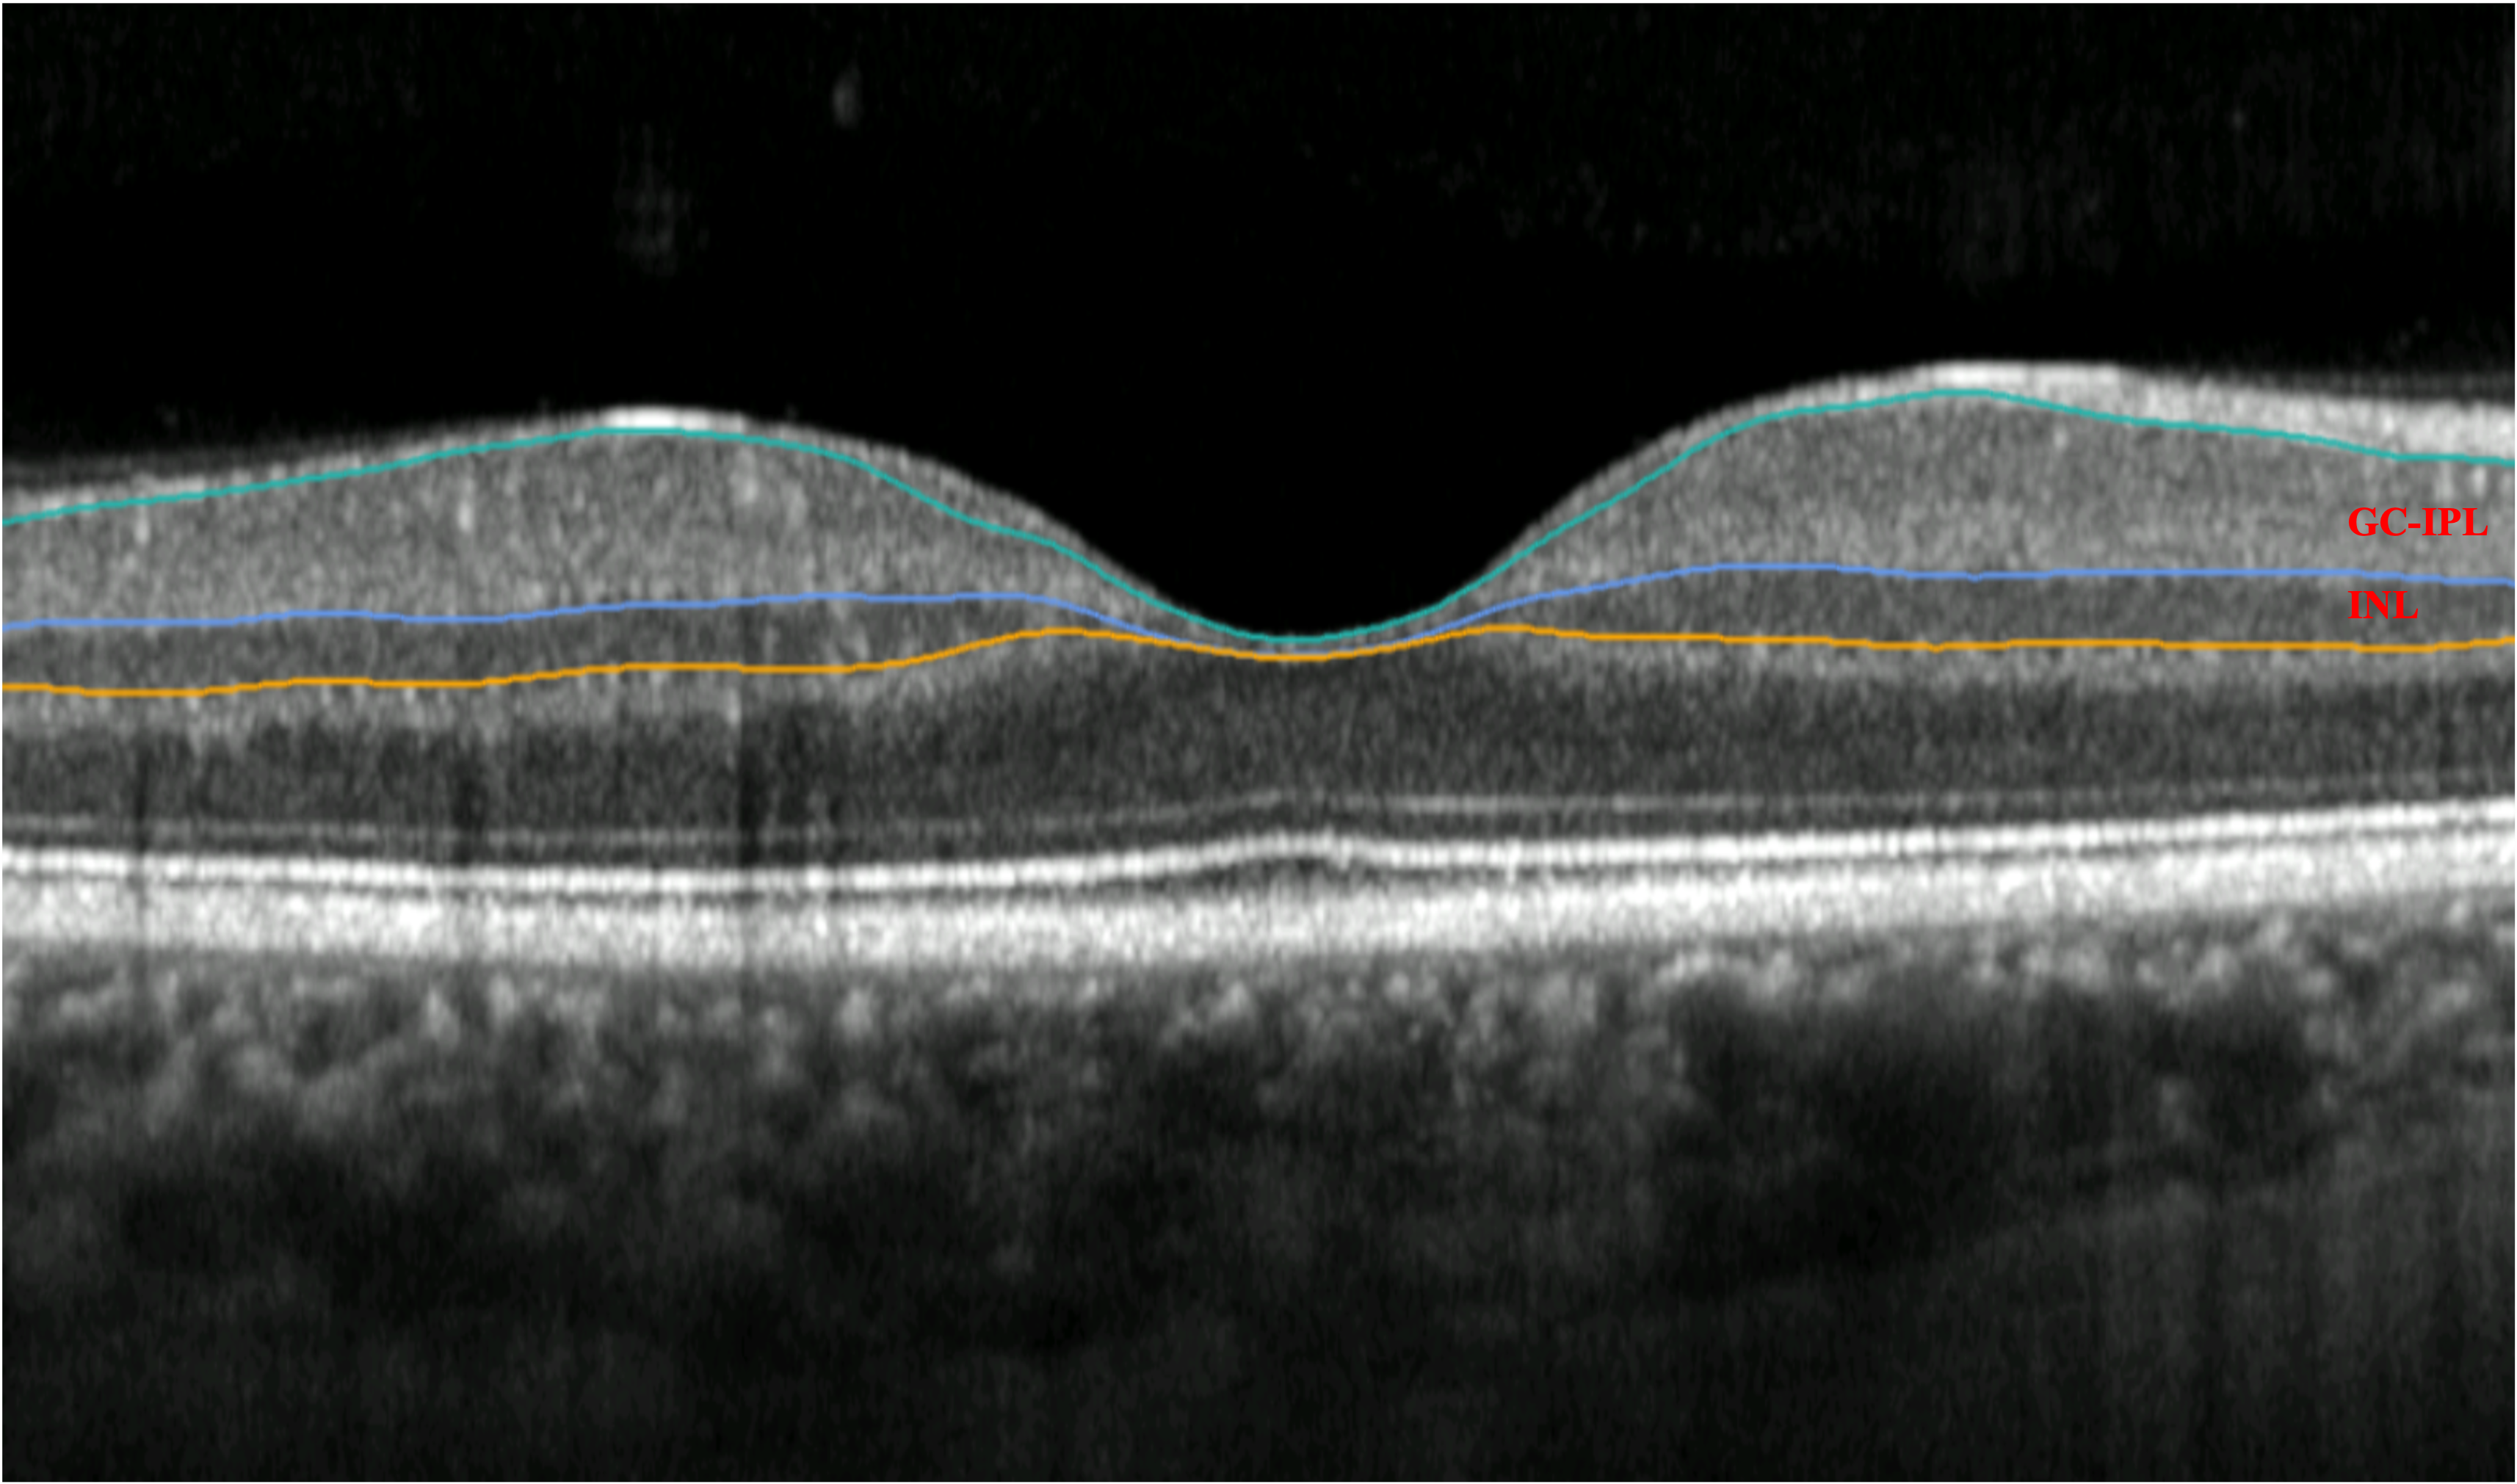

Optical coherence tomography analysis of measurements of cystoid macular lesions showed that patients with different IRD phenotypes can develop very large CMLs.

Altris also has advanced AI models to enable vendor-neutral retina layers segmentation as well as detection and visualization of more than 70 retina conditions such as dry and wet age-related macular degeneration, geographic atrophy, diabetic retinopathy, diabetic macular edema and central retinal vein occlusion.

David Huang, MD, PhD, receives Lasker Award for transformative imaging technology

Optical coherence tomography analysis of measurements of cystoid macular lesions showed that patients with different IRD phenotypes can develop very large CMLs.
Researchers have identified markers that indicate the presence of Parkinson’s disease in patients an average of 7 years before the disease presents clinically.

According to Orbis International, the technology proves to be a practical solution in low-resource communities for tackling the leading cause of vision loss among working-age adults.

An experienced dermatologist blinded to clinical data performed the NVC using a videocapillaroscope VideoCap 3.0 (DSMedica) at 200× magnification in the study.

Shawn Kavoussi, MD, shared insights from his research on using infrared video for vitreous opacities and comparing postoperative reduction in vitreous opacity scores using infrared video with the Heidelberg spectralis unit.

The companies plant to create a comprehensive resource that provides valuable insights into health outcomes, medication adherence, and the effectiveness of various treatment protocols.

Research has found a new approach that identifies high-risk infants, so that not all preemies need to undergo an invasive eye exam.

The investigators have developed a clinically robust HH-SECTR system, which has a modular aluminum probe design and micrometer-scale mechanical stability.

A single, consistent modality leads to better geographic atrophy tracking.

The retina is a peripheral part of the central nervous system and shares many similarities with cerebral brain matter.

Optos announced the first ultra-widefield color rgb (red/green/blue) image. This new image modality is captured simultaneous to the optomap color rg image.

This medical device is the first retinal eye-movement monitor for non-invasive, objective clinical assessments.

Dierck Hillmann, PhD, was interviewed by our onsite team at the 2023 ARVO annual meeting where he shared research on holographic optical coherence tomography (OCT).

At the 2023 ARVO annual meeting in New Orleans, our on-site team caught up with T. Y. Alvin Liu, MD, to discuss predictive AI and its application in ophthalmology and screening of the eyes.

David Szanto, a medical student at Stony Brook, and working with the Department of Neurology at the Icahn School of Medicine at Mount Sinai, describes how an algorithm finds recurring patterns in the visual fields and the ganglion cell-inner plexiform layer thicknesses, and helps clinicians understand how prevalent those patterns are throughout the entire data.

The various aspects of home monitoring for patients with age-related macular degeneration are discussed in this point/counterpoint by Prof. Rufino Silva, University of Coimbra / Coimbra Hospital and University Centre, Portugal, and Univ.-Prof. Dr. med. Robert P. Finger, PhD, Department of Ophthalmology, University of Bonn, Germany, during the 14th annual Congress on Controversies in Ophthalmology in Lisbon, Portugal.

Imaging biomarkers are useful to determine the degree of EZ attenuation in the fovea.

Delegates will analyze the most relevant and controversial issues within the field of ophthalmology at this year’s congress in Lisbon, Portugal, from March 24 to 25.

Artificial intelligence (AI) with ultra-widefield fundus autofluorescence images may be helpful to objectively estimate progression of retinitis pigmentosa (RP) and visual function.

A team of researchers have found that STOC tomography enables unprecedented views of eye structure.

Artificial intelligence in a primary care and clinic settings increases the likelihood of catching diabetic retinopathy in underinsured patients, resulting in increased successful referrals.

David Eichenbaum, MD, FASRS, shared difficult cases of diabetic macular edema (DME) and age-related macular degeneration (AMD) and insights into patient care.

In both patients and controls, investigators measured retinal nerve fiber layer thickness, foveal avascular zone area, and vessel density in the superficial capillary plexus, deep capillary plexus, and radial peripapillary capillary plexus.

Data highlights need for educational materials and training resources in DME and DR.

In this cross-sectional study, investigators used OCTA to identify possible associations between body mass index and the waist-to-hip ratio with macular vessel density and foveal avascular zone in healthy Chinese adults.